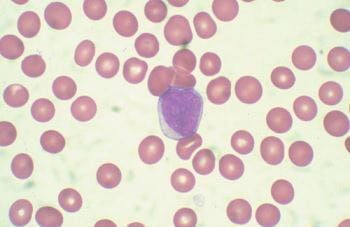

The Alliance A091902 trial is currently investigating paclitaxel with and without nivolumab in patients who are taxane naive and nivolumab plus cabozantinib in taxane-pretreated patients.

The Alliance A091902 trial is currently investigating paclitaxel with and without nivolumab in patients who are taxane naive and nivolumab plus cabozantinib in taxane-pretreated patients.

This new analysis of nivolumab presented at ASCO 2024 shows the immune checkpoint inhibitor did not convery benefit when added to a regimen of neoadjuvant carboplatin, paclitaxel, and radiation.

An in-depth analysis of minimal residual disease (MRD) negativity results from the PERSEUS trial shows patients whose treatment regimen included subcutaneous daratumumab had responses that deepened over time.

Results for the first 10 patients offer promising signs for giving patients with multiple myeloma a prophylactic dose of tocilizumab before they are treated with the bispecifc antibody teclistamab.

The findings can help reduce barriers that delay the onset of recommended palliative care in advanced cancer.

The idea that patients could get better responses with shorter courses of therapy runs counter to the current standard of care in melanoma.

Within the GAIN-S model, geriatric care assessments among older patients with cancer are combined with care interventions, and it is delivered soon before patients have an intervention on their cancer therapy, says William Dale, MD, PhD, FASCO, City of Hope.

A pair of late-breaking trials, LAURA and ADRIATIC, promise practice-changing news in lung cancer.

The BE-a-PAL study investigated potential of an algorithm-based default palliative care referral among patients who have stage III or IV lung or noncolorectal gastrointestinal cancer.

Attendees packed a session on multicancer early detection (MCED) on the first day of the 2024 American Society of Clinical Oncology annual meeting.

The annual session on newly approved drugs reviewed adverse effects, mechanisms of action, and real-world experiences.

Glofitamab is currently being investigated in a phase 1/2, multicenter, open-label, dose-escalation study as monotherapy and in combination with obinutuzumab, following 1-time fixed-dose pretreatment with obinutuzumab for B-cell non-Hodgkin lymphoma, of which mantle cell lymphoma (MCL) is a rare type.

The TROPiCS-02 trial studied sacituzumab govitecan vs physician’s choice of chemotherapy for HR+/HER2– breast cancer.

Topics at the upcoming meeting of the American Society of Clinical Oncology include the impact of artificial intelligence and the best way to deliver palliative care.

In this interview ahead of the 2024 American Society of Clinical Oncology annual meeting (ASCO), Ravin Ratan, MD, MEd, The University of Texas MD Anderson Cancer Center, discusses study data he is excited to hear more about on the combination of trabectedin and low-dose irinotecan for relapsed/refractory Ewing sarcoma.

Two abstracts presented at the 2023 American Society of Clinical Oncology annual meeting evaluated biosimilar adoption across oncology practices and highlighted the role payers play in preventing or promoting adoption.

Speakers elaborated on health care delivery and regulatory policy posters presented at the 2023 American Society of Clinical Oncology (ASCO) Annual Meeting. This article will appear in the ASCO recap edition of Evidence-Based Oncology.

The study's lead author said patients would experience improved quality of life due to fewer transfusions and fewer trips to the clinic to receive treatment.
Presentations on the first day of the 2023 American Society of Clinical Oncology Annual Meeting covered data on a split dose CAR T-cell therapy and a CAR T therapy manufactured with TKI.

Abstracts were presented in a session on metastatic lung cancer on the final day of the 2023 American Society of Clinical Oncology Annual Meeting.

The study was conducted to provide insight into real-world Bruton tyrosine kinase (BTK) inhibitor treatment patterns in mantle cell lymphoma, as current data are limited.

A panel of experts at the American Society of Clinical Oncology Annual Meeting presented the latest research and equity considerations for chimeric antigen receptor (CAR) T-cell therapy in hematological cancers.

A session chaired by ASCO and ESMO leadership included experts on the latest lung and colorectal cancer screening technologies and persistent disparities in screening access and uptake.

Initiating targeted therapy for eligible patients with advanced non–small cell lung cancer (NSCLC) was found to improve outcomes, even when patients were started on nontargeted therapy but switched in a timely manner.

The therapy is designed to target multiple receptors and could address an unmet need in metastatic colorectal cancer.

A second study will evaluate the treatment and financial burden and quality of life of a program of subcutaneous daratumumab administered at home.

A study presented at the American Society of Clinical Oncology Annual Meeting found practice- and provider-level racial and ethnic inequities in rates of next-generation sequencing (NGS) testing for patients with advanced non–small cell lung cancer (NSCLC) treated in the community setting.

An abstract at the American Society of Clinical Oncology Annual Meeting showed disparities in lung cancer screening rates in an urban, multiethnic community, and patient navigation increased rates overall.

The autologous CAR T-cell therapy axicabtagene ciloleucel (axi-cel) demonstrated effectiveness and safety consistent with the ZUMA-5 trial when used in real-world settings to treat a broader population of patients with follicular lymphoma (FL).

Barb Kunz, MS, LCGC, senior genetic counselor at the US Oncology Network, discussed the importance of germline genetic testing in patients with triple-negative breast cancer and other cancer types.

259 Prospect Plains Rd, Bldg H
Cranbury, NJ 08512
© 2025 MJH Life Sciences®
All rights reserved.
